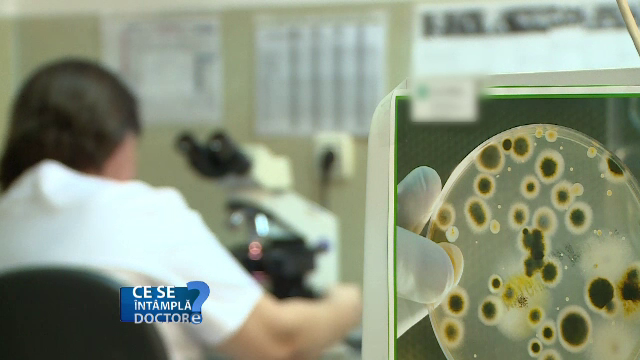
bacterii

Puteti face o investigatie RMN chiar daca aveti implanturi dentare. Care sunt riscurile de pierdere a unui dinte pus astfel
Imi fac un implant, o sa mai pot apela la testarea tip RMN? Da, este rapunsul pe care il dau medicii. Imensul magnet pe baza caruia se face RMN-ul nu interactioneaza cu titanul, materialul din care sunt facute implanturile.
Toate dispozitivele medicale introduse in corpul uman sunt realizate din titan. Metalul nu este atras de magnet, asa ca nu exista sa nu puteti face un RMN in caz ca ati trecut printr-un implant de acest gen.
Dr. Ionut Leahu, medic dentist: "Cand vin sa isi faca impaturi ma intreaba, mai trec la aeroport sau nu? Nu bipaie la aeroport daca aveti implanturi. Titanul nu este magnetizabil, asta e un aspect foarte important."

Dispozitivele medicale care se introduc in organismul uman - atat protezele, cat si implanturile dentare - sunt relizate din titan, un metal care nu contine fier. Implicit, magnetul nu il atrage.
Dr. Ionut Leahu, medic dentist: "Pot sta linistiti si pot sa beneficieze de o imagistica corecta, nu exista niciun risc pentru sanatatea lor daca au nevodie de o investigatie RMN."
In privinta implanturilor dentare, riscul il reprezinta doar igiena defectuoasa ulterioara. Lasate sa se inmulteaza exagerat, bacteriile din cavitatea orala pot duce la pierderea implantului.
Explicam: In interiorul organismului uman populatii largi de bacterii au o viata sociala activa. Comunica intre ele si au capacitatea de a crea comunitati. Odata ce incep “discutiile”, bacteriile devin constiente de densitatea lor. Creaza asa numitul bio-film. Adica secreta o pelicula invincibila in jurul lor. Risc mare de a se dezvolta acest biofilm apare in jurul dispozitivelor medicale introduse in organism.
Dr. Maria Nica, medic primar medicina de laborator: "Sunt dispozitive medicale din materiale inerte. Medicina moderna a intervenit cu solutii salvatoare, dar bacteriile s-au adaptat. Intotdeauna cand un tratament antibiotic nu are efect, clinuicianul trebuie sa se gandeasca la biofilm."
La ora actuala, o solutie o reprezinta ultrasunetele, care distrug filmul bacterian
























